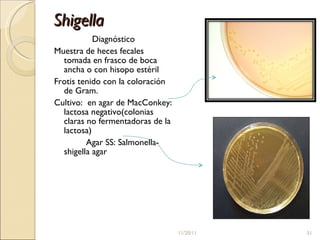
Shigella Diagnóstico Muestra de heces fecales tomada en frasco de boca ancha o con hisopo estéril Frotis tenido con la coloración de Gram. Cultivo:  en agar de MacConkey: lactosa negativo(colonias claras no fermentadoras de la lactosa) Agar SS: Salmonella-shigella agar 11/20/11

El documento detalla las características, distribución y patogenicidad de las enterobacterias, incluyendo géneros como Escherichia, Klebsiella, Proteus, Salmonella y Yersinia. Se destacan las infecciones que causan, así como sus métodos de diagnóstico y tratamiento, enfatizando la identificación de cepas patógenas y el manejo de la enfermedad. También se aborda la importancia de la prevención y el saneamiento en la control de estas infecciones.